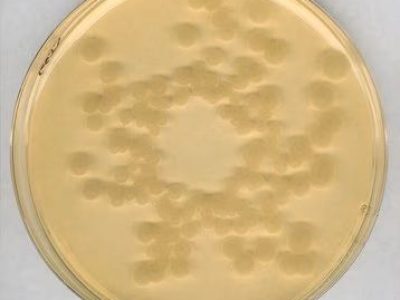
خرید محیط کشت RCA, Reinforced clostridial agar, 105410 , RCA , 1054100500

محیط کشت سیمون سیترات اگار
فروش محیط کشت سیمون سیترات اگار (به انگلیسی : Simmons Citrate Agar) با کد 103855 برند مرک اصل با کیفیتی تضمینی در آرمان کیمیا زیست، تامین کننده مواد شیمیایی آزمایشگاهی با بیش از ۳۰ سال سابقه، جهت خرید محیط کشت سیمون سیترات اگار با ما تماس بگیرید یا شماره تماس خود را وارد نمائید تا کارشناسان فروش در اسرع وقت با شما تماس بگیرند
جدول خصوصیات محلول
| دیگر نامها |
SIMMONS citrate agar acc. ISO 10273 and FDA-BAM GranuCult® prime |
|---|---|
| حجم | , |
| کشور سازنده |
آلمان |
| کمپانی سازنده |
سیگما الدریچ (Sigma-Aldrich) ,مرک (Merck) |
| کد محصول | , |
محیط کشت سیمون سیترات اگار چیست؟
محیط کشت سیمونز سیترات آگار (به انگلیسی: Simmons Citrate Agar) با کد ۱۰۳۸۵۵ یکی از محیطهای کشت مهم و کاربردی در آزمایشگاههای میکروبیولوژی است. این محیط کشت جهت شناسایی و تمایز باکتریهایی که قادر به استفاده از سیترات به عنوان منبع کربن هستند، مورد استفاده قرار میگیرد. از این رو، محیط کشت سیمونز سیترات آگار در آزمونهای تشخیصی میکروبی، خصوصاً در شناسایی اعضای خانواده انتروباکتریاسه (Enterobacteriaceae) از اهمیت ویژهای برخوردار است.
ویژگیهای فیزیکوشیمیایی
محیط کشت سیمونز سیترات آگار شامل ترکیباتی از جمله سیترات آمونیوم، سدیم کلرید، دی فسفات پتاسیم، منو فسفات آمونیوم، بروموتیمول بلو و آگار است. این ترکیبات به گونهای طراحی شدهاند که به شناسایی دقیق باکتریها کمک میکنند. بروموتیمول بلو به عنوان شاخص pH عمل میکند و در صورت استفاده باکتریها از سیترات، تغییر رنگ ایجاد میکند. محیط کشت در pH معادل ۶.۹ آمادهسازی میشود و پس از اتوکلاو در دمای ۱۲۱ درجه سانتیگراد به مدت ۱۵ دقیقه، آماده مصرف میگردد.
این محیط کشت شامل ترکیبات زیر است:
- سیترات آمونیوم: به عنوان منبع نیتروژن
- سیتریک اسید: به عنوان منبع کربن
- بروموتیمول بلو: به عنوان معرف pH
محیط کشت سیترات آگار دارای رنگ سبز است که در صورت مصرف سیترات توسط باکتریها، رنگ آن به آبی تغییر میکند. این تغییر رنگ به دلیل تولید قلیاییها و افزایش pH محیط است.
کاربردها
این محیط کشت به طور خاص در آزمایشگاههای میکروبیولوژی برای:
- شناسایی و تمایز باکتریهای انتروباکتریاسه: باکتریهایی که توانایی استفاده از سیترات به عنوان منبع کربن را دارند، رشد کرده و رنگ محیط به دلیل تولید قلیایی تغییر میکند.
- آزمونهای تشخیصی در آزمایشگاههای بالینی: استفاده در شناسایی پاتوژنهای میکروبی مختلف از جمله گونههای سالمونلا و شیگلا.
- تحقیقات میکروبیولوژیک: استفاده در پروژههای تحقیقاتی مرتبط با متابولیسم باکتریها و بررسی تواناییهای متابولیک آنها.
حجمها و بستهبندی
محیط کشت سیمونز سیترات آگار با کد ۱۰۳۸۵۵ در بستهبندیهای مختلفی عرضه میشود که شامل:
- ۵۰۰ گرم: مناسب برای آزمایشگاههای کوچک و متوسط.
- ۲.۵ کیلوگرم: مناسب برای آزمایشگاههای بزرگ و مراکز تحقیقاتی.
مزایا
- تشخیص سریع و دقیق: این محیط کشت به دلیل تغییر رنگ سریع، امکان تشخیص سریع باکتریهای رودهای را فراهم میکند.
- کاربرد گسترده: قابل استفاده در آزمایشگاههای میکروبیولوژی، صنایع غذایی و دارویی.
- سهولت در استفاده: آمادهسازی ساده و سریع این محیط کشت، آن را به یکی از ابزارهای مهم در تشخیصهای میکروبی تبدیل کرده است.
نتیجهگیری
محیط کشت سیمونز سیترات آگار با کد مرک ۱۰۳۸۵۵ یکی از ابزارهای ضروری برای آزمایشگاههای میکروبیولوژی است که با ویژگیهای فیزیکوشیمیایی خاص و کاربردهای گسترده، امکان تشخیص و شناسایی سریع و دقیق باکتریهای رودهای را فراهم میکند. این محصول در بستهبندیهای متنوع و مناسب برای نیازهای مختلف آزمایشگاهی عرضه میشود.